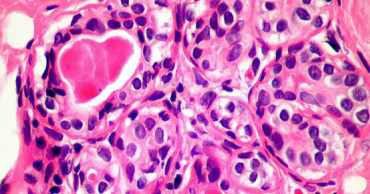
Immune discovery 'may treat all cancer'

immune system
How to Keep Your Baby Comfortable and Healthy While Using Air Conditioner or Cooler
In Bangladesh's hot weather, air conditioners (ACs) and coolers often become necessities to beat the heat. However, as a parent, ensuring your baby’s comfort and wellbeing in such environments can be tricky. Babies are more sensitive to temperature changes, and without proper care, they might catch a cold. So, how do you balance the need for cooling while keeping your baby healthy?
Why Babies Catch Cold Under ACs
Babies Have Weaker Immune Systems
Babies, especially newborns, have developing immune systems. This means they are more susceptible to catching colds and infections, which can be triggered by their surrounding ambients, such as exposure to cold air from ACs.
Rapid Temperature Changes
One key reason babies catch cold under ACs is the rapid shift from warm to cool temperatures. Imagine stepping out of a hot, humid day into a chilled room—you will feel the difference immediately. For babies, such abrupt changes in temperature can hurt their respiratory system, making them more prone to colds and related illnesses.
Read more: How to comfortably travel with babies
Dry Air in AC Rooms
ACs tend to remove moisture from the air and make the room dry. Babies’ nasal passages can get dried out, making them more vulnerable to respiratory issues and colds. They may also experience dry skin, which can lead to discomfort.
Babies' Inability to Regulate Body Temperature
Unlike adults, babies cannot regulate their body temperature effectively. This means they might feel colder or warmer than you do under the same conditions. Though a room’s temperature might seem comfy for grown-up children and adults, it can be too cold for a baby, increasing risk of catching a cold.
1 year ago
Microgreens: Nutrition, Health Benefits, and How to Grow
In a world where healthy eating and sustainable farming practices are gaining prominence, microgreens emerge as a nutritional powerhouse and an excellent addition to any diet. These tiny greens not only pack a punch in terms of health benefits but also offer a cost-effective solution for farming enthusiasts. This article will delve into the world of microgreens, their origins, health advantages, nutritional components, and how one can cultivate them in our country.
What are Microgreens?
Microgreens are the young, edible seedlings of various vegetables and herbs, tracing their roots back to California in the 1980s. Far from accidental, their invention resulted from meticulous research aimed at maximising the nutritional value of plants in their early growth stages.
Harvested at around 1-3 inches tall, one week aged, these tiny greens offer an incredible concentration of flavour and nutrients. They often contain 40 times more nutrients than their mature counterparts, making them a popular choice for those seeking both taste and health benefits. Easy to cultivate at home, microgreens have become a trendy and versatile culinary delight.
Read more: 10 Types of Natural Honey: A Guide to Varieties, Benefits, and Uses
Nutritional Components of Microgreens: Superfood of the Future
These seedlings are rich in a bunch of vitamins including Vitamin C, Vitamin K, Protein, Carbohydrates, Fibre, Sodium, Iron, Selenium, Magnesium, Manganese, etc.
Due to the high nutritional value, microgreens are also referred to as "superfood".
2 years ago
US OK’d extra Covid vaccine dose for those with weak immune systems
U.S. regulators say transplant recipients and others with severely weakened immune systems can get an extra dose of the Pfizer or Moderna COVID-19 vaccines to better protect them as the delta variant continues to surge.
The late-night announcement Thursday by the Food and Drug Administration applies to several million Americans who are especially vulnerable because of organ transplants, certain cancers or other disorders. Several other countries, including France and Israel, have similar recommendations.
It’s harder for vaccines to rev up an immune system suppressed by certain medications and diseases, so those patients don’t always get the same protection as otherwise healthy people — and small studies suggest for at least some, an extra dose may be the solution.
Also read: The link between the COVID-19 vaccine and pregnancy
“Today’s action allows doctors to boost immunity in certain immunocompromised individuals who need extra protection from COVID-19,” Dr. Janet Woodcock, the FDA’s acting commissioner, said in a statement.
The FDA determined that transplant recipients and others with a similar level of compromised immunity can receive a third dose of the vaccines from Pfizer and Moderna at least 28 days after getting their second shot. The FDA made no mention of immune-compromised patients who received the single-dose Johnson & Johnson vaccine.
The announcement comes as the extra-contagious delta version of the coronavirus surges through much of the country, pushing new cases, hospitalizations and deaths to heights not seen since last winter.
Importantly, the FDA’s decision only applies to this high-risk group, estimated to be no more than 3% of U.S. adults. It’s not an opening for booster doses for the general population.
Also read: Moderna says vaccine 93% effective but seeks 3rd-shot in fall
Instead, health authorities consider the extra dose part of the initial prescription for the immune-compromised. For example, France since April has encouraged that such patients get a third dose four weeks after their regular second shot. Israel and Germany also recently began recommending a third dose of two-dose vaccines.
Separately, U.S. health officials are continuing to closely monitor if and when average people’s immunity wanes enough to require boosters for everyone — but for now, the vaccines continue to offer robust protection for the general population.
The Centers for Disease Control and Prevention is expected to formally recommend the extra shots for certain immune-compromised groups after a meeting Friday of its outside advisers.
Transplant recipients and others with suppressed immune systems know they’re at more risk than the average American and some have been seeking out extra doses on their own, even if it means lying about their vaccination status. The change means now the high-risk groups can more easily get another shot — but experts caution it’s not yet clear exactly who should.
“This is all going to be very personalized,” cautioned Dr. Dorry Segev, a transplant surgeon at Johns Hopkins University who is running a major National Institutes of Health study of extra shots for organ recipients. For some people, a third dose “increases their immune response. Yet for some people it does not seem to. We don’t quite know who’s who yet.”
One recent study of more than 650 transplant recipients found just over half harbored virus-fighting antibodies after two doses of the Pfizer or Moderna vaccines — although generally less than in otherwise healthy vaccinated people. Another study of people with rheumatoid arthritis and similar autoimmune diseases found only those who use particular medications have very poor vaccine responses.
There’s little data on how well a third dose works, and if it causes any safety problems such as an increased risk of organ rejection. Wednesday, Canadian researchers reported that transplant recipients were more likely to have high levels of antibodies if they got a third dose than those given a dummy shot for comparison. Other small studies have similarly found that some transplant recipients respond to a third dose while others still lack enough protection.
4 years ago
Wellbeing during COVID-19: How yoga can help you during quarantine
The ongoing global pandemic of COVID-19 has recently been creating even more havoc with its more contagious and powerful Delta variant and Bangladesh has been recording new highs in the daily death toll almost every day over the past week.
People are exploring the possible remedies and immunity boosters to stay healthy amid the shutdown, including the benefits of home workouts, meditations and yoga.
Fatigue is something that does not go away even after COVID-19 is cured, and it is also a companion to other infectious diseases. People suffering from weakness of body and mind cannot easily return to normal life because of this respiratory virus that affects the lungs and causes a lack of oxygen supply, thus fatigue spreads to the cells of the body.
Read:Bangladeshi youth shines in global yoga vlogging contest
Evaluating the problem, health experts suggest that the lungs need to be protected as well as the immune system of the body, and regular yoga practice can be an effective solution to these necessities and also helps to prevent fatigue and other physical and psychological problems.
Several organizations including Dhaka Metropolitan Police (DMP) are considering yoga a beneficiary tool for the frontliners policemen and it has arranged multiple yoga training sessions over the year for both of its male and female troops.
Regarding the health benefit of yoga during this pandemic, Monirul Islam, a 70-years old retired government officer, talked to UNB and shared his miraculous recovery process of surviving a stroke, from which he got cured by practising yoga during the lockdown last year.
Read Which Type of Yoga Should You Try?
“I have always been a fit and socially active person, being engaged to many organizations and cooperative works after my retirement. When we were instructed by WHO and the government that we need to avoid all the outside activities, embracing all these new normalcies and lockdown protocols, my regular life and health got massively impacted - as a result of which, I suffered a stroke in August 2020,” Monirul Islam told UNB.
After receiving the necessary medical assistance, he started receiving online training from yoga studio Bend with B’s founder and instructor Bishaka Tanchangya, a certified yoga instructor from Swami Vivekananda Yoga Anusandhana Samsthana (SVYASA Yoga University), Bangalore, India.
Read:What Does Yoga Do For Weight Loss?
4 years ago
Aussie study makes vital breakthrough in fight against deadly sepsis
Australian researchers have made a vital breakthrough in combating the deadly sepsis, identifying the gene which triggers cell death and inflammation in sufferers.
5 years ago
Immune discovery 'may treat all cancer'
A newly-discovered part of our immune system could be harnessed to treat all cancers, say scientists and reports BBC.
6 years ago



.jpg)


.jpg)